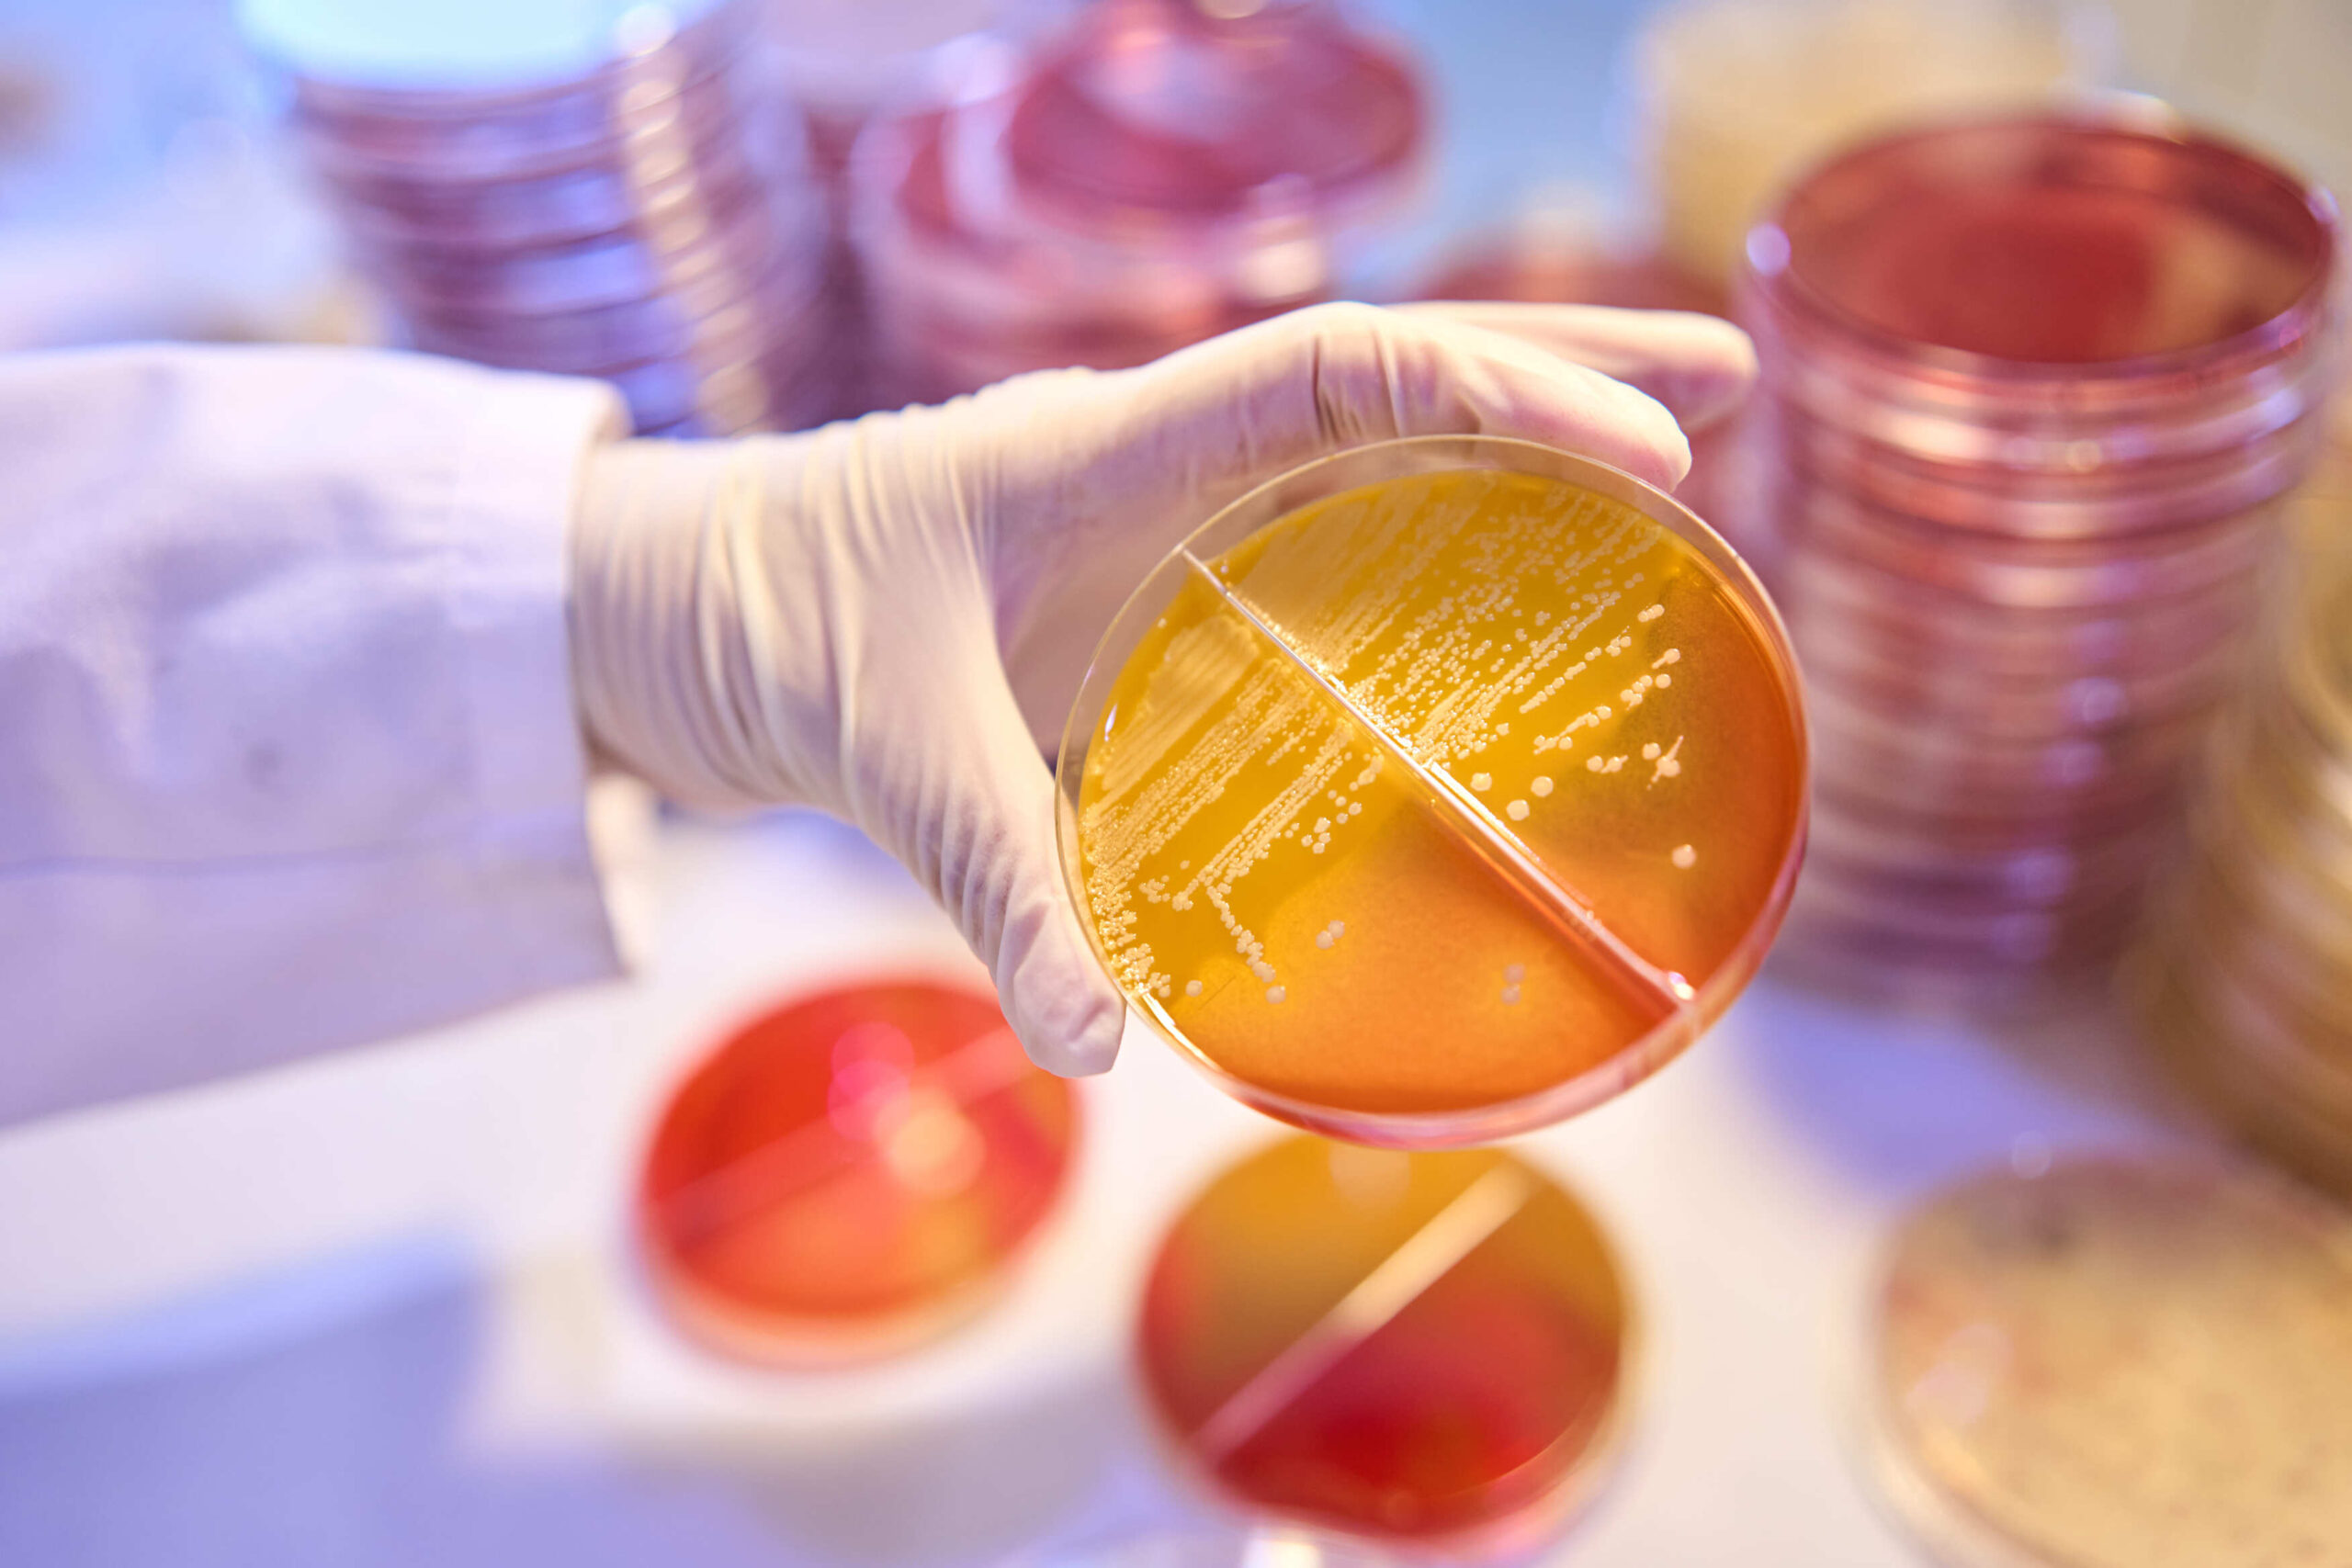

Inicio / Consultoría
¿QUÉ ES UN ESTUDIO DE VIDA ÚTIL DE ALIMENTOS?
Es un estudio realizado en laboratorio que incluye ensayos microbiológicos, fisicoquímicos y sensoriales (color, olor,
sabor…) con el fin de determinar la vida útil de un alimento.
La determinación de la vida útil de un alimento asegura al consumidor que el producto mantiene los niveles de calidad sensorial adecuados y es microbiológicamente seguro y al fabricante le permite cumplir con la normativa.
La normativa de referencia (Reglamento UE 1169/2011) obliga a fabricantes a aportar este tipo de estudios que
demuestren la estabilidad microbiológica del alimento en el periodo indicado en la etiqueta, especialmente en los
alimentos listos para el consumo y con atención particular a la presencia de patógenos como Listeria
monocytogenes, conforme al Reglamento 2073/2005.
A través del estudio de vida útil se fijan las fechas de caducidad y las fechas de consumo preferente
Diferencias entre fecha de consumo preferente y fecha de caducidad
- La fecha de consumo preferente es la fecha a partir de la cual las propiedades fisicoquímicas y
sensoriales de un alimento empiezan a modificarse y son percibidas de forma negativa por el consumidor. - La fecha de caducidad es la fecha a partir de la cual un alimento ya no es apto para su consumo y
podría ser perjudicial para la salud.
Asesoramiento en diseño higienico de instalaciones
- Ofrecemos asesoramiento en el diseño de instalaciones de cocinas de hoteles y restaurantes que permitan garantizar un adecuado flujo de procesos, y la aplicación de buenas prácticas en la elaboración de alimentos


TIPOS DE ESTUDIO DE VIDA ÚTIL DE ALIMENTOS
Una de las dudas más frecuentes es el tiempo en el que un fabricante puede obtener resultados de la vida útil de los productos que pretende lanzar al mercado.
Existen estudios diferentes para la gran oferta de alimentos que existen en el mercado. Veamos cuales son los más
importantes:
Estudios de Vida útil en tiempo real
Es el estudio que se realiza en alimentos perecederos con una vida útil inferior a 6 meses, obteniendo un resultado de
forma inmediata, sin necesidad de someter al alimento a condiciones especiales.
En ellos, se conserva el alimento en sus condiciones habituales de almacenamiento y se estudian las variaciones en los parámetros microbiológicos, fisicoquímicos y sensoriales evaluados en diferentes tiempos.
Estudios de vida útil acelerados
Es el estudio que se realiza en alimentos no perecederos, con una vida útil superior a 6 meses o en aquellos en los que se requieren resultados urgentes.
Se llevan a cabo almacenando los alimentos en unas condiciones forzadas y analizándolos en diferentes momentos,
hasta que se alteran a límites sensoriales inaceptables.

MICROBIOLOGIA PREDICTIVA, ESTUDIO EN TIEMPO REAL COMPLEMENTARIO
Basado en modelos matemáticos y estadísticos para predecir el comportamiento de los microorganismos en el alimento en función de su naturaleza, el pH, la temperatura, la actividad de agua, composición etc.
Esta metodología irá siempre acompañada de estudios complementarios :
- ANALISIS MICROBIOLÓGICOS
- ANALISIS SENSORIAL
- Basado en realizar un análisis sensorial del producto al principio, mitad y final de su vida útil. Para
evaluar posibles alteraciones que hicieran el producto no seguro según el Reglamento (CE) 178/2002
- Basado en realizar un análisis sensorial del producto al principio, mitad y final de su vida útil. Para

ANÁLISIS SENSORIAL
Los análisis sensoriales consisten en la evaluación objetiva de productos alimentarios a través del sentido humano bien entrenado. Las pruebas sensoriales implican métodos científicos para comprobar el aspecto, la textura, el olor y el sabor de un producto.
Los órganos sensoriales (ojos, nariz, boca, piel y oídos) perciben y analizan las características del producto. Las pruebas
sensoriales se utilizan para evaluar los productos alimentarios con el fin de garantizar que el consumidor reciba un
producto de alta calidad que atraiga sus sentidos y que haya sido previamente analizado con métodos científicos.
Así, las pruebas sensoriales se llevan a cabo en las áreas de desarrollo de productos, control de calidad e
investigación. También ayudan a determinar la vida útil mínima de un producto para detectar la obsolescencia o el
deterioro de los alimentos. Las pruebas sensoriales se realizan para estandarizar los productos y adaptarlos a las normas y expectativas de los consumidores. De este modo, se puede aumentar la tasa de éxito en el lanzamiento de nuevos productos u optimizar los productos existentes.
Las evaluaciones sensoriales sirven para controlar y garantizar la calidad deseada al termino de la vida útil del alimento desde el punto de vista organoléptico,
¿PORQUÉ SON IMPORTANTES LOS ANÁLISIS SENSORIALES?
El objetivo de una evaluación sensorial es proporcionar al departamento de investigación de un producto información
científica sobre las propiedades sensoriales del mismo.
Además, la evaluación sensorial sirve para controlar y mantener una calidad específica y definida del producto.
LAS PRUEBAS SENSORIALES SE RECOMIENDAN ESPECIALMENTE PARA:
- La evaluación de la comerciabilidad de un producto.
- La descripción exacta de las características del producto (por ejemplo, pruebas de perfil)
- El examen de la estabilidad en el almacenamiento (examen de la fecha de consumo preferente, MHD)
- La comparación y el posicionamiento de los productos.
- La gestión de las reclamaciones (tratamiento de las reclamaciones)
- Las modificaciones del producto.
- El desarrollo de nuevos productos.
En nuestro laboratorio le ofrecemos estudios de vida útil conforme a lo establecido en Reglamento (CE) 2073/2005
relativo a los criterios microbiológicos aplicables a los productos alimenticios.
Nuestros estudios se realizan conforme a lo dispuesto en el anexo II del mimos reglamento para investigar el cumplimiento de los criterio a lo largo de toda la vida útil.




¿POR QUÉ ES IMPORTANTE CONOCER LA VIDA ÚTIL DE LOS ALIMENTOS?
- PARA CUMPLIR LOS CRITERIOS MICROBIOLÓGICOS Y DE SEGURIDAD ALIMENTARIA.
- EVITAR RECLAMACIONES DE CONSUMIDORES.
- LANZAMIENTOS DE UN NUEVO PRODUCTO.
- GARANTIAR LA INOCUIDAD Y SEGURIDAD DEL PRODUCTO AL TERMINO DE SU VIDA ÚTIL.
- EVITAR INMOVILIZACIONES DE PRODUCTO.


